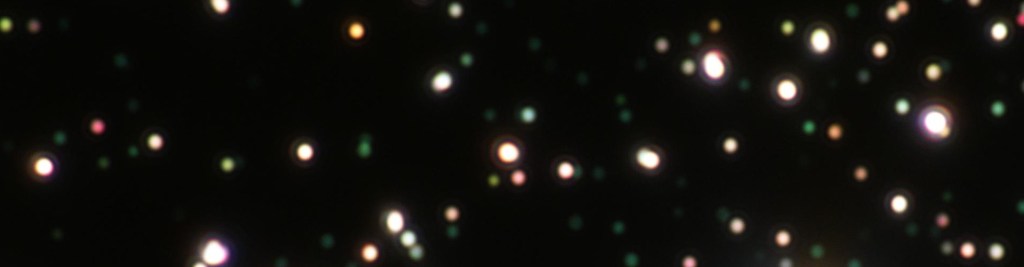

Les étudiants diplômés du M2 MIO sont majoritairement embauchés sur des postes d’ingénieurs dans des entreprises de la photonique ou d’autres entreprises technologiques. Ils occupent des postes d’ingénieurs en Recherche et Développement (R&D), d’ingénieurs de production, d’ingénieurs qualité, d’ingénieurs commerciaux.
- 61 % des diplômés sont embauchés comme ingénieurs dans une entreprise
- 30 % des diplômés poursuivent avec une thèse (bourse de thèse ministérielle ou bourse de thèse CIFRE)
- 4,1 mois, c’est le temps moyen pour trouver un emploi après le diplôme MIO

Lire également l’excellent dossier rédigé par l’ONISEP et Photonics France sur Les métiers de l’électronique et de la photonique.
Des témoignages sur les métiers de la photonique
Des exemples d’emplois occupés par les diplômés MIO
- Ingénieur système pour Safran Electronics & Defense
- Ingénieur Optronique chez Thalès (Inde)
- Thèse à l’Observatoire de Paris (SYRTE) sur les horloges atomiques
- Ingénieur en microscopie & programmateur scientifique : Développement d’un module de microscopie de super-résolution (employé par Astek)
- Ingénieur R&D l’Oréal
- Ingénieur de production en Fibre optique. Rhone Télécom, sous-traitant SFR
- Thèse à l’ENSSAT Lannion en opto-électronique
- Thèse à I’Institut des NanoSciences de Paris sur la photoluminescence de nanocristaux
- Ingénieur R&D sur un projet de Maquillage chez Chanel
- Thèse sur la couleur et les effets visuels des objets du patrimoine au MNHN
- Ingénieur dans la société Trimble (3D laser scanner)
- Ingénieur Fibre Optique chez SFR
- ingénieur qualité chez Horiba-Jobin Yvon
- Thèse CIFRE à l’institut d’électronique et de télécommunications de Rennes
Données 2019
- Thèse à l’Institut Fresnel de Marseille sur la Microscopie optique bi-modale super-résolue
- Thèse en plasmonique moléculaire à l’UTT de Troyes
- Ingénieur Optoélectronique chez Cementys
- Thèse CIFRE en nano-optique et électronique quantique dans la start-up Nexdot
- Ingénieur qualité pour la société Laser Systems & Solutions of Europe (LASSE)
- Ingénieur dans la société Amplitude Systèmes (Bordeaux)
Ingénieur réseau optique chez INTERDATA - Ingénieur ALTEN, chez Safran Electronics & Defense
- Thèse au LOA de l’Ecole Polytechnique sur les lasers ultra-bref de très haute intensité
- Technology analyst chez Yole Developpement
- Ingénieur Altran pour Safran Electronics & Defense
- ingénieur R&D au sein de la société Laser Systems & Solutions of Europe (LASSE)
- Research Engineer at CIMEL ELECTRONIQUE
- Ingénieur spécialiste en traitement d’images dans la société Astek
- Thèse CIFRE chez ST Microelectronics